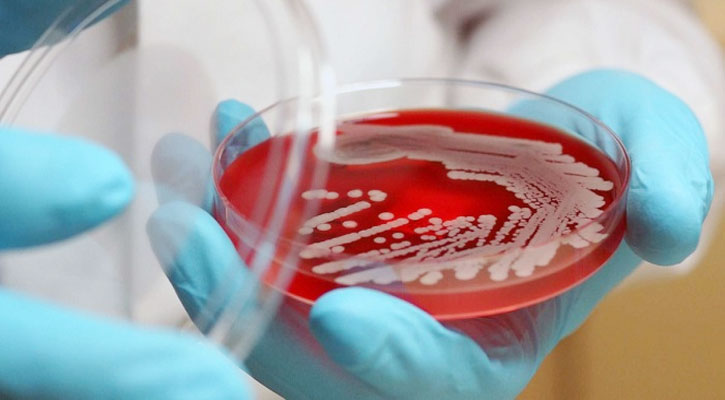
অ্যান্টিবায়োটিকের ভুল ব্যবহারে সুপারবাগের শঙ্কা

- ঢাকা
- সোমবার, ১৫ জুন, ২০২৬,
ঢাকা : অপ্রয়োজনে অ্যান্টিবায়োটিকের ব্যবহার ও ভুল ডোজের কারণে জীবাণু যেভাবে ওষুধ প্রতিরোধী হয়ে উঠছে তাতে যে কোনো সময় বড় ধরনের স্বাস্থ্য বিপর্যয় ডেকে আনতে পারে। এতে অ্যান্টিবায়োটিক রেসিস্ট্যান্স বা সুপারবাগ আবির্ভাবের শঙ্কা করছেন বিশেষজ্ঞরা।
তাই অ্যান্টিবায়োটিকের অপব্যবহার রোধে এখনি জরুরি পদক্ষেপ নিতে হবে। প্রেসক্রিপশন ছাড়া অ্যান্টিবায়োটিক বিক্রি বন্ধ করতে হবে।
বিশ্ব স্বাস্থ্য সংস্থার মতে, বর্তমানে যে হারে অ্যান্টিবায়োটিক ব্যবহার করা হয় তার অর্ধেকের বেশি অপ্রয়োজনীয়। অ্যান্টিবায়োটিকের অপব্যবহার নিয়ন্ত্রণ করতে না পারলে, বড় বিপর্যয় হতে পারে।
সম্প্রতি বৈশ্বিক এক প্ল্যাটফর্মে প্রধানমন্ত্রী শেখ হাসিনা বলেছেন, জীবাণু যেভাবে ওষুধ প্রতিরোধী হয়ে উঠছে তাতে কার্যকর অ্যান্টিবায়োটিকের ঘাটতি এক সময় বড় ধরনের স্বাস্থ্য বিপর্যয় নিয়ে আসতে পারে।
যুগের পর যুগ বৈজ্ঞানিক গবেষণার মাধ্যমে আমাদের চিকিৎসা ও স্বাস্থ্য সেবায় যে সাফল্য এসেছে, তা ম্লান করে দিতে পারে এটা।
বিশেষজ্ঞদের মতে, আমাদের দেশে অপ্রয়োজনীয় অ্যান্টিবায়োটিকের ব্যবহার অনেক বেশি। দেশে রেজিস্ট্রার ডাক্তারের সংখ্যা ৯০ হাজারের মতো। ৬৫ থেকে ৭০ হাজার ডাক্তার নিয়মিত রোগী দেখেন। তারা প্রায়ই প্রেসক্রিপশনে অ্যান্টিবায়োটিক সেবনের পরামর্শ দেন রোগীদের। দেশে আড়াই লাখের মতো ওষুধ বিক্রির দোকান আছে। বিক্রেতারাও কোনো কিছু না জেনেই রোগীকে অ্যান্টিবায়োটিক দিচ্ছেন।
দেশের প্রত্যন্ত অঞ্চলে নিয়ম নীতির তোয়াক্কা না করে প্রশাসনকে বৃদ্ধাঙ্গুলি দেখিয়ে ফার্মেসি সাইনবোর্ড লাগিয়ে ওষুধ বিক্রি করা হয়। পল্লী চিকিৎসকদের একটি বড় অংশ নির্বিচারে রোগীকে অ্যান্টিবায়োটিক সেবান করান।
এ বিষয়ে জনস্বাস্থ্য বিশেষজ্ঞ ডা. লেলিন চৌধুরী বলেন, প্রয়োজন ছাড়াই অ্যান্টিবায়োটিকের অপব্যবহারে রেসিস্ট্যান্স আবির্ভাব হওয়ার একটা আশঙ্কা তৈরি হয়েছে, যে জীবাণুকে আমরা সুপারবাগ বলছি।
অলরেডি মাল্টিড্রাগ রেসিস্ট্যান্স পৃথিবীতে চলে এসেছে, যেটি ওষুধে কাজ করছে না। চিকিৎসা বিজ্ঞানীরা এ বিষয়ে আগ থেকেই সতর্ক করে আসছিলেন। তাই বিশ্বব্যাপী অ্যান্টিবডি ব্যবহারের কিছু গাইডলাইন তৈরি হচ্ছে। এটা সবারই ফলো করা উচিত।
আমরা এমন কিছু রোগী পাচ্ছি, যারা অ্যান্টিবায়োটিক রেসিস্ট্যান্স। আইসিইউতে বেশ কিছু রোগীর শরীরে কোনো অ্যান্টিবায়োটিক কাজ করছে না।
তিনি আরো বলেন, বাংলাদেশে অপ্রয়োজনীয় অ্যান্টিবায়োটিকের ব্যবহার অনেক অনেক বেশি হচ্ছে। এটি নিয়ন্ত্রণ করা দরকার। এর জন্য নির্দেশনা থাকা জরুরি।
নিয়ম করতে হবে, কোনো ওষুধের দোকান প্রেসক্রিপশন ছাড়া অ্যান্টিবায়োটিক বিক্রি করতে পারবে না, এমবিবিএস ডাক্তার ছাড়া অ্যান্টিবায়োটিক সেবনের পরামর্শ কেউ দিতে পারবেন না। ডিপ্লোমাধারী ডাক্তারেরা চার বা ছয়টার বেশি অ্যান্টিবায়োটিক লিখতে পারবেন না। এর জন্য মনিটরিং হওয়া উচিত। মেডিকেল প্র্যাকটিসের ক্ষেত্রে গুড প্র্যাকটিস চালু করতে হবে।
এ বিষয়ে কোভিড-১৯ বিষয়ক জাতীয় কারিগরি পরামর্শক কমিটির সদস্য ও বঙ্গবন্ধু শেখ মুজিব মেডিকেল বিশ্ববিদ্যালয়ের সাবেক উপাচার্য অধ্যাপক ডা. নজরুল ইসলাম বলেন, অ্যান্টিবায়োটিক ব্যবহারের আগে অবশ্যই অ্যান্টিবায়োটিক সেনসিটিভিটি টেস্ট করতে হবে। সেটা না করেই লোকে আন্দাজমতো ব্যবহার করেন।
আরেকটা বিষয়, মানুষ অ্যান্টিবায়োটিকের ফুল কোর্স শেষ করে না, ডোজও ঠিক মতো মেইনটেইন করে না। এভাবে রেসিস্ট্যান্স ফর্ম করার সুযোগ তৈরি হয়।
ডাক্তাদের মধ্যে একটা প্রবণতা আছে, সেনসিটিভিটি টেস্ট না করেই অ্যান্টিবায়োটিক দেয়া। রোগীর ব্যাকটেরিয়া সংক্রমণ হলে রোগীকে ল্যাবে পাঠাতে হবে, তার জন্য কোন অ্যান্টিবায়োটিক দরকার সেটা জানতে হবে।
সোনালীনিউজ/এমটিআই







































